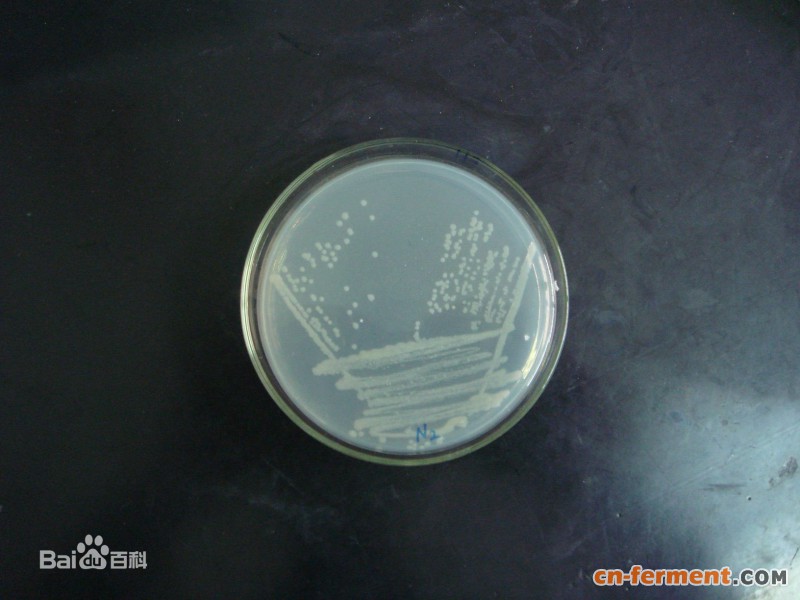

项目概况
丙酮酸(Pyruvic acid),又称2-氧代丙酸(2-oxopropanoic acid)、α-酮基丙酸(α-ketopropionic acid)或乙酰基甲酸(Acetylformic acid),是最重要有机酸之一。在制药、食品、化工、农用化学品等领域以及科学研究中都具有广泛的用途。丙酮酸在生物能量代谢中具有十分重要的作用,丙酮酸系列的衍生产品,包括丙酮酸甲酯、丙酮酸乙酯、丙酮酸肌酸盐、丙酮酸钙、丙酮酸钾、丙酮酸钠、丙酮酸镁等,在医药、化工等领域应用广泛,同时也是多种化工产品、农药等的原料。丙酮酸(盐)及其衍生物的用途主要包括以下几个方面:
(1)制药工业:用于酶法合成L-色氨酸、L-酪氨酸、L-多巴胺;合成 L-半胱氨酸、L-亮氨酸、维生素B6和B12等;合成血管紧张肽Ⅱ抗药、系列酶蛋白抑制剂、镇静剂、辛可芬、异烟肼丙酮酸钙、2-苯基喹啉-4-羧酸、恩波吡维铵、磷酸烯醇丙酮酸、4-甲唑甲酸、噻咪等。另外,丙酮酸钙还可用作减肥保健药品。
(2)日化工业:丙酮酸乙酯可抑制表皮中的酪氨酸酶的形成,美白肌肤;可用作化妆品的防腐剂和抗氧化剂;用作空气清新剂。
(3)农用化学品:合成乙烯系聚合物、氢化阿托酸、谷物保护剂等多种农药的起始原料。
(4)食品/饲料工业:GB2760-1996 规定为酸味添加剂;作为添加剂具有防腐保险功能。
(5)细胞培养与生化研究:与乳酸组成抗氧化剂,降低对细胞的伤害;丙酮酸钠可以作为细胞培养中的替代碳源,是动物细胞培养的重要底物。用于伯醇及仲醇的鉴定、转氨酶的测定、脂肪族胺的显色剂等。
丙酮酸的工业生产方法主要有化学合成法、酶转化法和微生物发酵法。化学合成法主要为在液相或气相中将酒石酸(或乳酸酯)氧化为丙酮酸酯,水解成丙酮酸,但该方法污染重,成本高,缺乏竞争力。其它还有一些化学转化法如羟基丙醇法,乳酸氧化法等均由于原料不足或成本缺乏工业化可行性。酶转化法是利用微生物细胞中的酶系将乳酸等脱氢氧化为丙酮酸该方法转化率高、但底物成本高。微生物发酵法是利用低成本的葡萄糖作为底物生物发酵生产丙酮酸。目前研究的微生物主要包括酵母、担子菌、放线菌和细菌等。我们通过构建新型大肠杆菌工程菌,实现了以葡萄糖为原料生产丙酮酸的高转化率发酵,该法绿色、环保、可持续,具有经济竞争力,有很好的产业应用前景。
市场前景
目前,全球丙酮酸市场需求约24000吨,按照丙酮酸的国内市场价约在5万元/吨左右,市场总值约12亿。我国有近10家企业生产丙酮酸及其盐、酯类,年产丙酮酸1000-1500吨,其中80%以上用于出口,同时国内丙酮酸市场的年增长率达到了8%-10%。随着工业应用领域的不断拓宽,丙酮酸用量也会急剧上升。自1995年美国等国以丙酮酸钙用于减肥保健以来,丙酮酸消费量激增。国际市场上,80%的丙酮酸用于制药工业,20%左右用于食品保健品及其它工业行业。因此丙酮酸产品的国际、国内市场缺口较大,加上国内市场需求量逐年增大,特别是高质量的丙酮酸尤其缺乏,其市场已进入高速成长期,销售前景广阔。
技术特点
利用先进代谢工程技术,通过从头理性设计和系统优化大肠杆菌,我们构建了生产丙酮酸的大肠杆菌工程菌。该菌株不含任何质粒,遗传稳定,以葡萄糖为碳源生产丙酮酸。目前在5L发酵罐水平,通过分批补料的方式,40小时发酵,丙酮酸产量可达到70g/L左右,基本不含副产物,转化率达到0.8g丙酮酸/g葡萄糖。
投资与效益分析
根据目前技术水平,初步估算丙酮酸的生产综合成本约2.5万元/吨,目前市场定价约为5万元/吨。以1000吨生产规模计算,毛利润可达2500万元/年。
研究阶段
小试阶段。